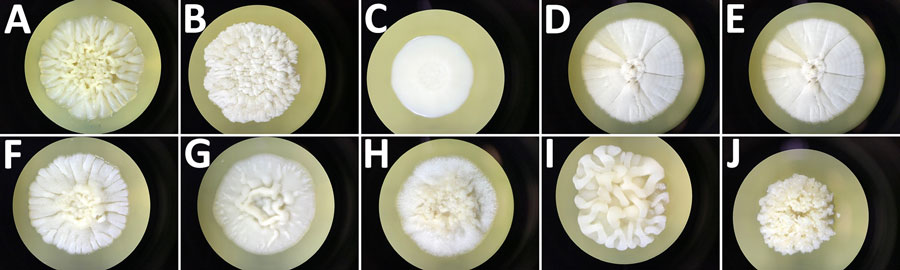
Macroscopic aspect of colonies grown on Sabouraud agar plates incubated 10 days at 20°C for 10 isolates recovered from study of clinical manifestations of emerging Trichosporon species infections, France, 2002–2022. A) T. asahii type strain isolate CBS 2479. B) T. austroamericanum isolate CNRMA20.443. C) T. inkin neotype strain isolate CBS 5585. D) T. coremiiforme type strain isolate CBS 2482. E) T. cf. coremiiforme isolate CNRMA19.523. F) T. faecale type strain isolate CBS 4828. G) T. cf. coremiiforme isolate CNRMA15.795. H) T. ovoides neotype strain isolate CBS 7556. I) T. caseorum type strain isolate CBS 9052. J) T. lactis isolate CBS 9051. T. coremiiforme and isolates corresponding to the potential T. cf. coremiiforme species (E, G) had the highest growth rate, whereas T. inkin and T. austroamericanum had reduced but similar growth rate. The cf. designation indicates putative undescribed species.

Clinical Manifestations of Emerging Trichosporon spp. Infections, France
Marie Desnos-Ollivier

, Alexandre Alanio, Maud Gits-Muselli, Karine Boukris-Sitbon, Agathe Bertho, Aude Sturny-Leclère, Emilie Guemas, Philippe Poirier, Christine Bonnal, Marie-Elisabeth Bougnoux, Sophie Brun, Taieb Chouaki, Nicole Desbois-Nogard, Elisabeth Chachaty, Florence Persat, Marc Pihet, André Paugam, Françoise Botterel, Magalie Demar, Loïc Favennec, Florent Morio, Frédéric Gabriel, Arnaud Fekkar, Jean-Pierre Gangneux, Caroline Mahinc, Valérie Letscher-Bru, Laurence Millon, Frédéric Dalle, Julie Bonhomme, Muriel Nicolas, Boualem Sendid, Milène Sasso, Laure Courtellemont, Anne-Laure Roux, Estelle Perraud-Cateau, Juliette Guitard, Edith Mazars, Olivier Lortholary, and Fanny Lanternier
Author affiliation: Institut Pasteur, Paris, France (M. Desnos-Ollivier, A. Alanio, K. Boukris-Sitbon, A. Bertho, A. Sturny-Leclère, O. Lortholary, F. Lanternier); Hôpital Saint-Louis, Paris (A. Alanio); Hôpital Robert Debré, APHP, Université Paris Cité, Paris (M. Gits-Muselli); Université Paris Cité, INSERM, IAME, Paris (M. Gits-Muselli); Centre National de la Recherche Scientifique, Toulouse, France (E. Guemas); Centre Hospitalier Universitaire Clermont-Ferrand, Clermont-Ferrand, France (P. Poirier); Université Blaise Pascal, Clermont-Ferrand (P. Poirier); Hôpital Bichat–Claude-Bernard, Paris (C. Bonnal); Hôpital Necker-Enfants Malades, Paris (M.-E. Bougnoux, O. Lortholary, F. Lanternier); Hôpital Avicenne, Bobigny, France (S. Brun); Centre Hospitalier Universitaire Amiens-Picardie, Amiens, France (T. Chouaki); University Hospital of Martinique, Fort-de-France, Martinique (N. Desbois-Nogard); Gustave Roussy, Villejuif, France (E. Chachaty); Centre Hospitalier Universitaire de Lyon, Lyon, France (F. Persat); CHU d'Angers, University Angers, University Brest, GEIHP, SFR ICAT, Angers, France (M. Pihet); Cochin Port Royal University Hospital AP-AP, Paris (A. Paugam); Université Paris-Est Créteil, Créteil, France (F. Botterel); Centre Hospitalier Andree Rosemon, Cayenne, Guyana (M. Demar); University Hospital Charles Nicolle, Rouen, France (L. Favennec); Nantes University Hospital, Nantes, France (F. Morio); Centre Hospitalier Universitaire de Bordeaux, Bordeaux, France (F. Gabriel); Centre d’Immunologie et des Maladies Infectieuses, Paris (A. Fekkar); Hôpital Pontchaillou, Rennes, France (J.-P. Gangneux); Centre Hospitalier Universitaire de Saint-Etienne, Saint-Etienne, France (C. Mahinc); Hôpitaux Universitaires de Strasbourg, Strasbourg, France (V. Letscher-Bru); University Hospital J Minjoz, Besancon, France (L. Millon); Dijon University Hospital, Dijon, France (F. Dalle); Centre Hospitalier Universitaire Côte de Nacre, Caen, France (J. Bonhomme); Centre Hospitalier Universitaire de Guadeloupe, Pointe-à-Pitre, Guadeloupe, France (M. Nicolas); Lille University Hospital Center, Lille, France (B. Sendid); Centre Hospitalier Universitaire Nîmes et Université de Montpellier, Nîmes, France (M. Sasso); Centre Hospitalier Universitaire d’Orléans, Orléans, France (L. Courtellemont); Assistance Publique-Hôpitaux de Paris, Boulogne-Billancourt, France (A.-L. Roux); Centre Hospitalier Universitaire Poitiers, Poitiers, France (E. Perraud-Cateau); Hôpital Saint-Antoine, Paris (J. Guitard); Centre Hospitalier de Valenciennes, Valenciennes, France (E. Mazars)
Main Article
Figure 5

Figure 5. Macroscopic aspect of colonies grown on Sabouraud agar plates incubated 10 days at 20°C for 10 isolates recovered from study of clinical manifestations of emerging Trichosporon species infections, France, 2002–2022. A) T. asahii type strain isolate CBS 2479. B) T. austroamericanum isolate CNRMA20.443. C) T. inkin neotype strain isolate CBS 5585. D) T. coremiiforme type strain isolate CBS 2482. E) T. cf. coremiiforme isolate CNRMA19.523. F) T. faecale type strain isolate CBS 4828. G) T. cf. coremiiforme isolate CNRMA15.795. H) T. ovoides neotype strain isolate CBS 7556. I) T. caseorum type strain isolate CBS 9052. J) T. lactis isolate CBS 9051. T. coremiiforme and isolates corresponding to the potential T. cf. coremiiforme species (E, G) had the highest growth rate, whereas T. inkin and T. austroamericanum had reduced but similar growth rate. The cf. designation indicates putative undescribed species.
Main Article
Page created: December 30, 2025
Page updated: January 29, 2026
Page reviewed: January 29, 2026
The conclusions, findings, and opinions expressed by authors contributing to this journal do not necessarily reflect the official position of the U.S. Department of Health and Human Services, the Public Health Service, the Centers for Disease Control and Prevention, or the authors' affiliated institutions. Use of trade names is for identification only and does not imply endorsement by any of the groups named above.